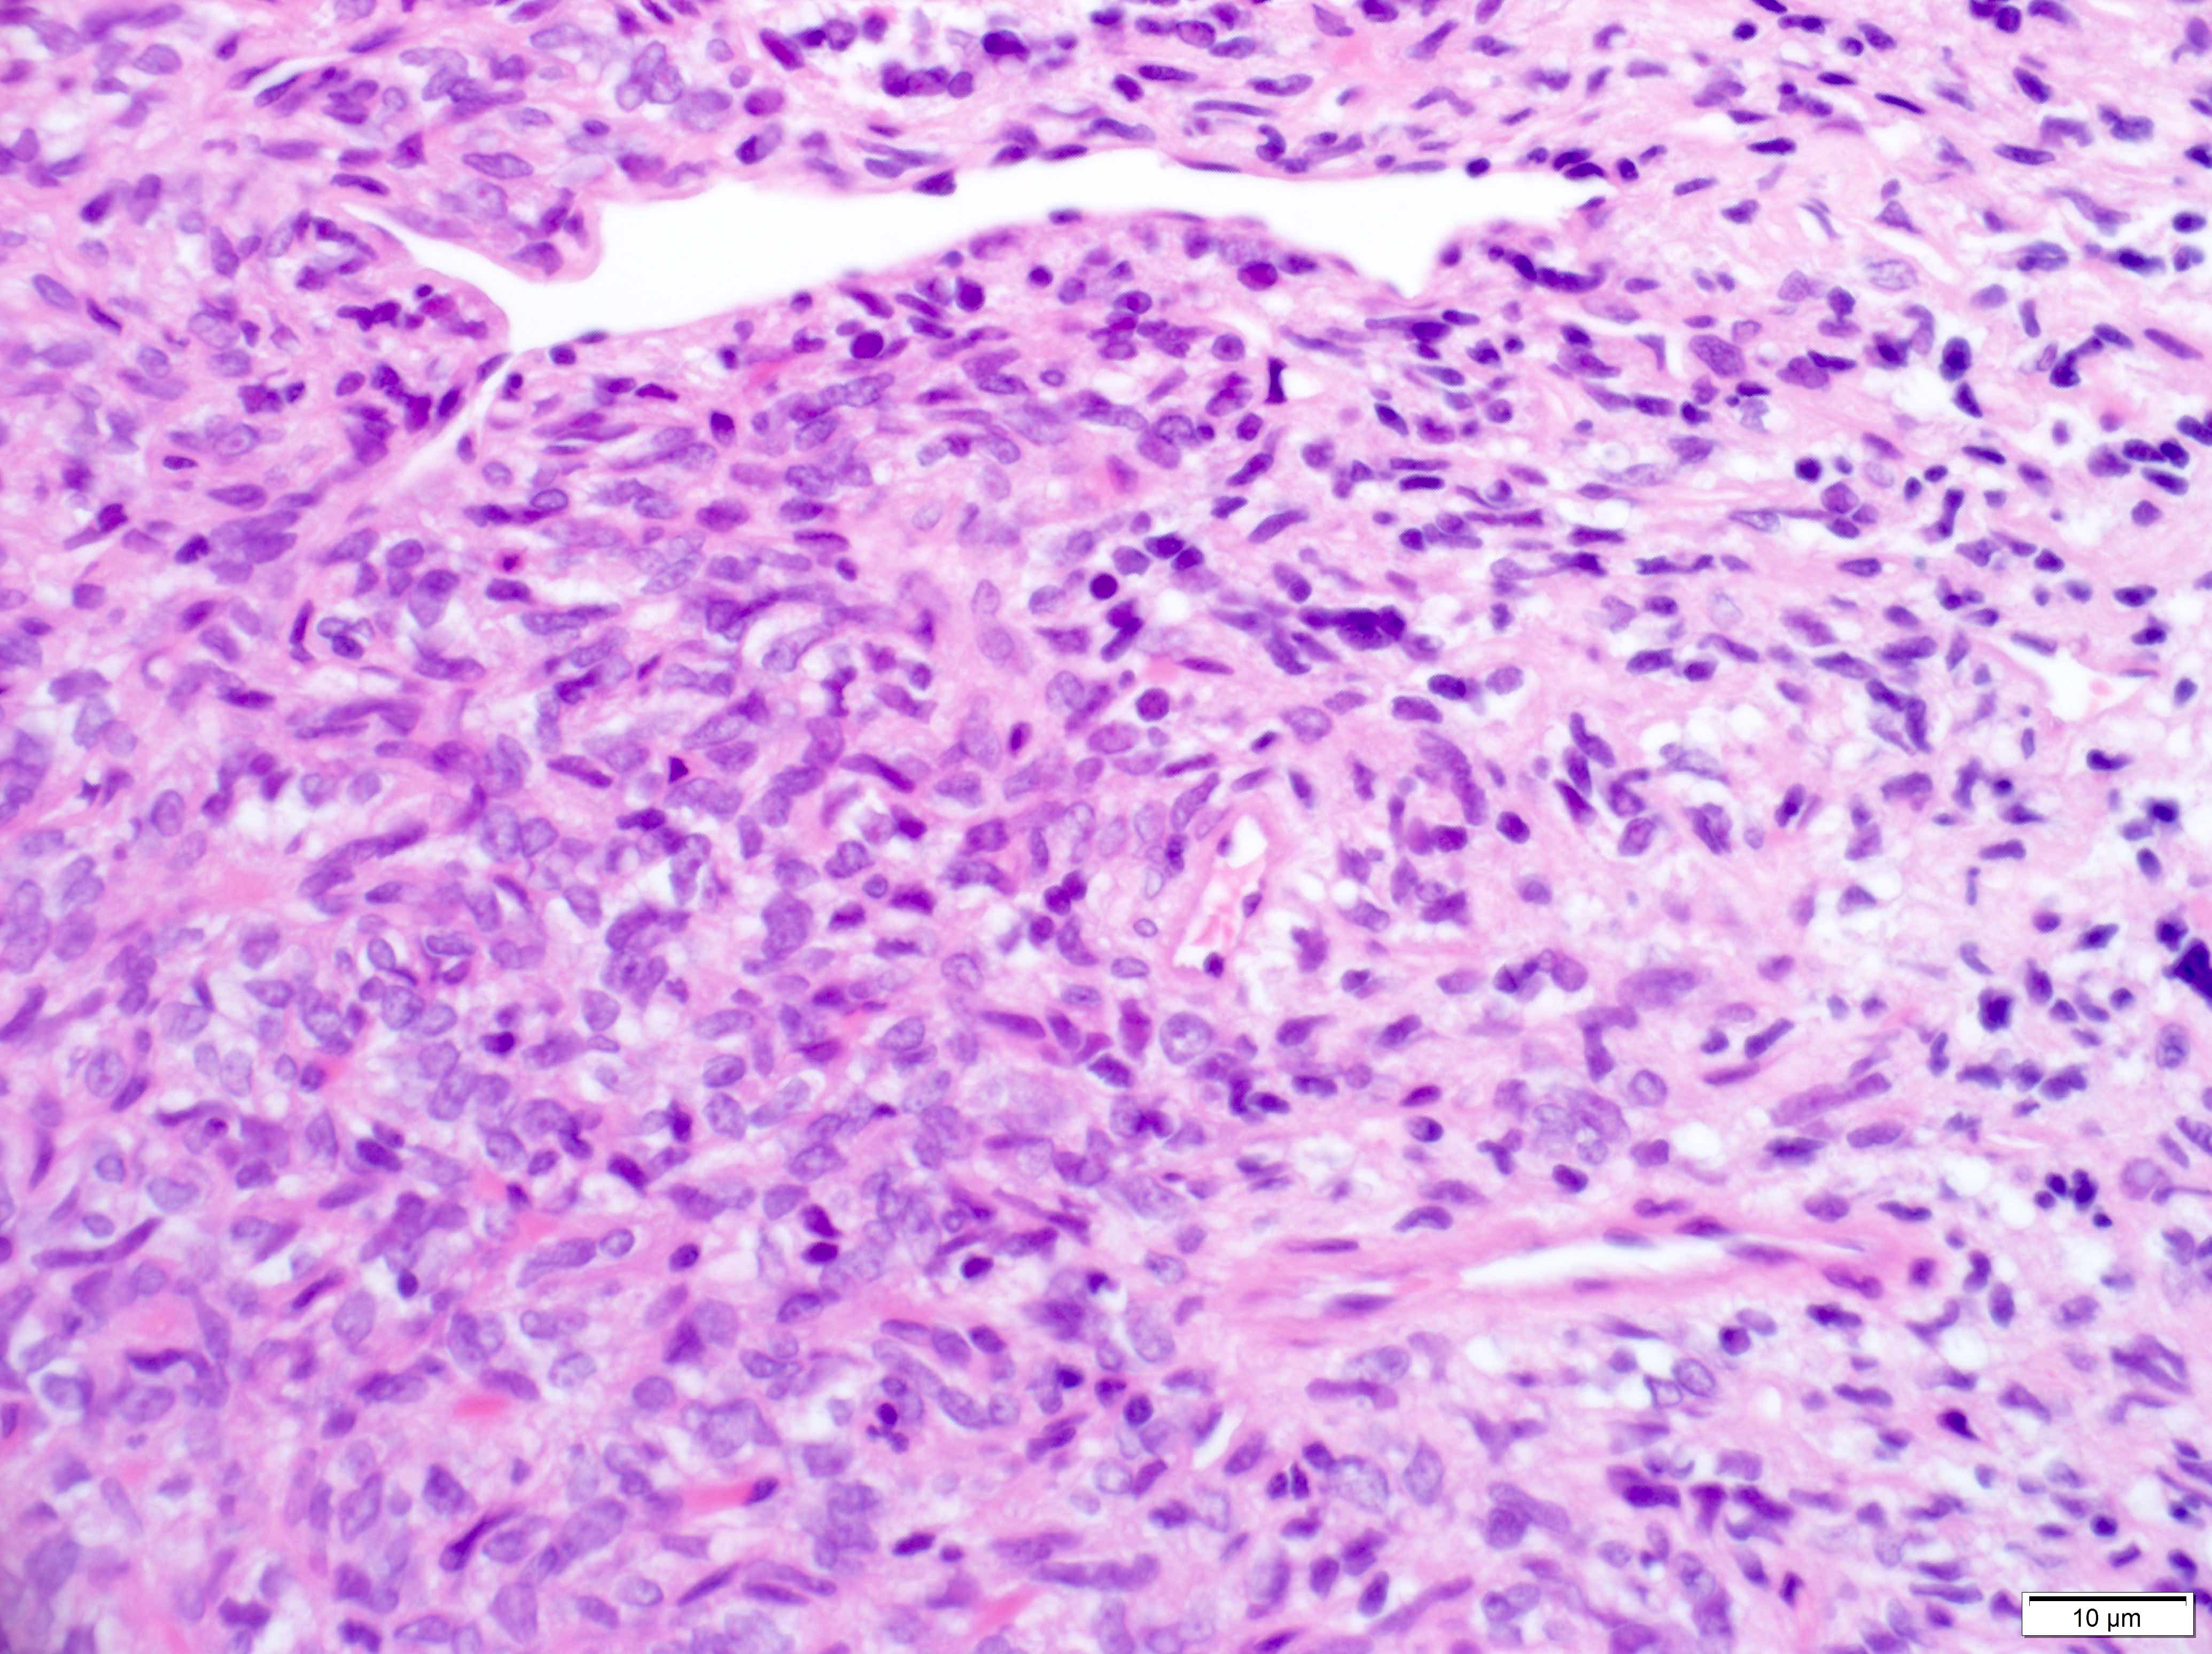

Table of Contents
Definition / general | Essential features | Terminology | ICD coding | Epidemiology | Sites | Pathophysiology | Etiology | Diagrams / tables | Clinical features | Diagnosis | Laboratory | Radiology description | Radiology images | Prognostic factors | Case reports | Treatment | Clinical images | Gross description | Gross images | Frozen section description | Intraoperative frozen / smear cytology images | Microscopic (histologic) description | Microscopic (histologic) images | Virtual slides | Cytology description | Positive stains | Negative stains | Molecular / cytogenetics description | Molecular / cytogenetics images | Videos | Sample pathology report | Differential diagnosis | Additional references | Practice question #1 | Practice answer #1 | Practice question #2 | Practice answer #2Cite this page: Crumley B, Schwetye K. Solitary fibrous tumor. PathologyOutlines.com website. https://www.pathologyoutlines.com/topic/cnstumorsft.html. Accessed September 21st, 2025.
Definition / general
- Solitary fibrous tumors (SFTs) of the CNS are spindle cell neoplasms with a wide range of histopathologic appearances and a pathognomonic NAB2::STAT6 fusion mutation with a characteristic immunophenotype
Essential features
- Spindle cell neoplasm that ranges in stromal collagenization and cellularity, often with a patternless pattern or dilated staghorn vessels
- Most common in the dura (especially the tentorium) but very rare compared to other primary meningeal tumors (Acta Neuropathol 2019;137:307)
- Pathognomonic NAB2::STAT6 fusion mutation that separates it from other tumors with similar microscopic appearances (Acta Neuropathol 2019;137:307)
- Positive IHC includes STAT6 (nuclear), CD34 and CD99
- Good prognosis but metastasis is possible, even with low grade tumors (Acta Neuropathol 2019;137:307)
Terminology
- Recent changes to the CNS WHO classification system have made solitary fibrous tumor the sole name for this entity (Neuro Oncol 2021;23:1231)
- Formerly called solitary fibrous tumor / hemangiopericytoma (SFT / HPC) and angioblastic meningioma
- Hemangiopericytoma has been removed from the most recent WHO CNS tumor classification
ICD coding
- ICD-O: 8815/1 - solitary fibrous tumor
- ICD-10 codes no longer listed by the WHO
- ICD-11: 2F7C & XH7E62 - neoplasms of uncertain behavior of connective or other soft tissue & solitary fibrous tumor, NOS
- ICD-11: 2B5Y & XH1HP3 - other specified malignant mesenchymal neoplasms & solitary fibrous tumor, malignant
Epidemiology
- < 5% of extra-axial CNS tumors (meningiomas are the most common) (J Clin Neurosci 2014;21:1310)
- Most common in patients in their 40s - 60s (Brain Pathol 2019;29:18)
- M:F = 1.08 (Brain Pathol 2019;29:18)
Sites
- Affects the dura most frequently (mainly found in the tentorium)
- Other sites include falx, other dural sites, skull base, cerebellum and pineal gland
Pathophysiology
- Pathognomonic NAB2::STAT6 fusion mutation on 12q13
- Exact pathogenesis of this neoplasm has not been fully elucidated apart from its spindle cell / fibroblastic nature
Etiology
- No known familial association
Clinical features
- Patients most commonly present with symptoms related to mass effect
Diagnosis
- Patients are given a preliminary, often nonspecific diagnosis from CNS imaging
- Found either during a primary workup or incidentally as part of a separate workup
- Typically made by (immuno)histologic examination but can be supplemented with molecular testing for the NAB2::STAT6 mutation
Laboratory
- Minority of cases present with hypoglycemia due to IGF1 production but this is nonspecific (Hum Pathol 1996;27:858)
Radiology description
- Common: dural tail sign (nonspecific) and clear demarcation from surrounding tissue
- Some cases will show a lack of obvious demarcation
- Isodense on noncontrast T1 weighted images but bright on T1 with contrast and T2 weighted images
- Meningiomas may also show a dural tail sign and similar enhancement patterns but are more likely to show intratumoral calcification and spoked wheel vessels (Neuroradiology 2021;63:1215)
Radiology images
Prognostic factors
- > 75% of patients survive 10 years after diagnosis, with shorter survival time associated with higher tumor grade (Neurosurg Rev 2021;44:1299)
- < 50% of tumors recur; the exact rate is cohort dependent (Neurosurg Rev 2021;44:1299)
- Literature is inconclusive as to whether spinal or brain tumors have a better prognosis (Neurosurg Rev 2021;44:1299, J Neurooncol 2019;143:457)
- SFTs can metastasize outside the CNS or to other locations within the CNS (13.3% according to one case review), with metastasis more likely in higher grade and spinal tumors (Neurosurg Rev 2021;44:1299)
- Differences in gene expression associated with increased vascular permeability are thought to increase metastasis risk compared to SFTs outside the CNS (Cancers (Basel) 2021;13:1142)
Case reports
- 10 year old boy with an intradural extramedullary tumor of the cervical spine (J Neurosurg Pediatr 2017;19:339)
- 26 year old woman with an extra-axial mass found during pregnancy, causing brain herniation (Case Rep Womens Health 2021;29:e00285)
- 45 year old woman with a tentorial mass in the right parieto-occipital region (Int J Surg Case Rep 2019;54:10)
- 53 year old woman with a spindle shaped extradural lesion in the cervical spine (BMC Surg 2021;21:405)
Treatment
- All tumors are treated with total resection
- Higher grade tumor treatment is often supplemented with adjuvant radiation
- Patients may be monitored for many years and even decades to evaluate for recurrence and metastasis
Gross description
- Discrete mass, often contiguous with dura, white to brown
- Gross appearance varies based on the relative amount of stromal collagen and tumor cellularity
- Some tumors can lose their dural attachment and infiltrate surrounding tissue (Ann Diagn Pathol 2003;7:169)
Frozen section description
- Characteristic feature: spindled cells without a single / discrete architecture (patternless pattern)
- Enlarged vascular spaces (staghorn vessels) can suggest SFT
- Typical frozen diagnosis: spindle cell neoplasm, with differential to include SFT, meningioma and possibly other (schwannoma, etc.) depending on location
Intraoperative frozen / smear cytology images
Microscopic (histologic) description
- Essential: patternless pattern of spindle cells, often solid but can also have papillary and other architectures, arranged around branching hyalinized vessels
- Varying amounts of stromal collagen and overall cellularity
- Nuclei are bland, without features seen in mimicking neoplasms
- WHO grading criteria:
- < 5 mitoses/10 high power fields (HPF) = grade 1
- ≥ 5 mitoses/10 HPF = grade 2
- ≥ 5 mitoses/10 HPF with necrosis = grade 3
- Often has staghorn vasculature
Microscopic (histologic) images
Virtual slides
Cytology description
- Lower grade tumors will show the characteristic patternless pattern but there is not a standardized list of cytology criteria for SFT diagnosis (J Pathol Transl Med 2019;53:192)
- Higher grade tumors can show sheets of monotonous cells with heterochromatic nuclei, often with rhabdoid cells and eosinophilic cytoplasm (J Pathol Transl Med 2019;53:192)
Positive stains
- CD34 (lost in some high grade tumors) (Am J Surg Pathol 1997;21:1354)
- STAT6 (nuclear, lost in some dedifferentiated tumors) (Int J Surg Pathol 2017;25:58)
- Vimentin
- CD99
- SMA (tumor periphery)
- BCL2
Negative stains
- SSTR2A
- S100 (up to 26% some S100 positivity in the CNS) (Iran J Pathol 2016;11:195)
- EMA (up to 29% some EMA positivity in the CNS) (Iran J Pathol 2016;11:195)
Molecular / cytogenetics description
- NAB2::STAT6 fusion mutation can be detected by sequencing, RT PCR or a proximity ligation assay
- NAB2 and STAT6 are close to each other on chromosome 12q, which can make genetic analysis difficult and the WHO considers a positive STAT6 immunostain to be sufficient for diagnosis in most cases (Nat Genet 2013;45:131)
Molecular / cytogenetics images
Videos
General overview of solitary fibrous tumors (not specific to CNS tumors) by Dr. Jerad Gardner
Sample pathology report
- Brain, tentorium, resection:
- Solitary fibrous tumor, CNS WHO grade 1 (see comment)
- Comment: Sections show a neoplasm composed of bland spindle cells within a heavily collagenized stroma, with 3 mitoses in 10 high power fields. A panel of immunohistochemical stains is strongly positive for CD34 and STAT6 (nuclear), with focal positivity for SMA and is negative for EMA and SSTR2A. These findings are consistent with a solitary fibrous tumor.
Differential diagnosis
- (Fibrous) meningioma (closest histologic mimic):
- Dural Ewing sarcoma:
- STAT6-, evidence of EWSR1 rearrangement
- Synovial sarcoma:
- Malignant peripheral nerve sheath tumor:
- Mesenchymal chondrosarcoma:
- Nests of STAT6- small round cells with rare cartilage islands
- Non-SFT metastasis:
- Immunophenotype of the primary tumor, STAT6-
Additional references
Practice question #1
Practice answer #1
D. SSTR2A. A is incorrect because ALDH1 stains are often positive in solitary fibrous tumors, with ALDH1 acting as a CD34 surrogate. B is incorrect because CD34 stains are positive in the vast majority of solitary fibrous tumors, with loss of expression seen in some higher grade tumors. C is incorrect because SMA can be expressed on the periphery of solitary fibrous tumors. SSTR2A is correct because this marker's positive staining in some meningiomas and complete lack of staining in solitary fibrous tumors can help distinguish between the two diagnostic entities.
Comment Here
Reference: Solitary fibrous tumor
Comment Here
Reference: Solitary fibrous tumor
Practice question #2
Practice answer #2
D. Tentorium. A, B and C are incorrect because while solitary fibrous tumors can be found in the cerebellum, pineal gland and spinal cord, it is not their most common location. D is correct because solitary fibrous tumors are most common in the dura, and the dural site they are most common in is the tentorium.
Comment Here
Reference: Solitary fibrous tumor
Comment Here
Reference: Solitary fibrous tumor